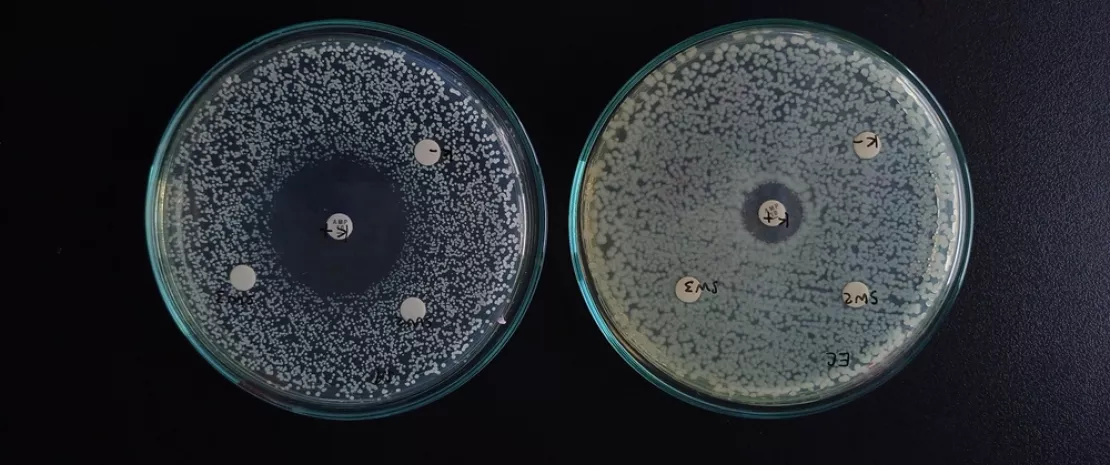

Un metabolito intestinal podría predecir el éxito del tratamiento CAR-T
Sabemos que los antibióticos perjudican los resultados del tratamiento con CAR-T. Pero, ¿por qué? Nuevos datos multicéntricos revelan que la microbiota intestinal, concretamente las bacterias productoras de butirato, es clave para el éxito del tratamiento en el linfoma no Hodgkin. El butirato circulante se perfila como biomarcador y como posible potenciador terapéutico, lo que está cambiando la forma en que preparamos a los pacientes para la terapia celular.
Espacio para el público general
Encuentra aquí tu espacio dedicado
en_sources_title
en_sources_text_start en_sources_text_end
Acerca de este artículo
La microbiota intestinal se ha revelado como un modulador fundamental de la inmunoterapia contra el cáncer, pero sus mecanismos exactos en la terapia con células CAR-T siguen sin estar claros. Un convincente estudio multicéntrico¹ publicado en Clinical Cancer Research demuestra ahora que un metabolito microbiano específico, el (sidenote: Butirato Un ácido graso de cadena corta producido por las bacterias intestinales mediante la fermentación de la fibra dietética. ) , podría constituir tanto un biomarcador pronóstico como una posible vía terapéutica para los pacientes con linfoma no Hodgkin (LNH) sometidos a tratamiento con células CAR-T contra el CD19.
Cuando los antibióticos afectan a más que a la infección
El estudio incluyó a 84 pacientes con LNH de cuatro centros y confirmó lo que sugerían cohortes estadounidenses y alemanas recientes: la exposición a antibióticos no profilácticos antes de la infusión de CAR-T perjudica significativamente la supervivencia libre de progresión. Los pacientes que recibieron dos o más líneas de antibióticos no profilácticos mostraron resultados notablemente peores, y los antibióticos de alto riesgo, como el meropenem, la cefazolina, la ceftriaxona y la piperacilina-tazobactam, mostraron las asociaciones negativas más fuertes.
Los investigadores del Hospital 12 de Octubre no se limitaron a establecer una correlación, sino que analizaron el mecanismo. Mediante la secuenciación del ARN ribosómico 16S de muestras de heces recogidas durante la linfaféresis, descubrieron que los pacientes expuestos a antibióticos presentaban índices de (sidenote: Diversidad de la microbiota La variedad y la uniformidad de las especies bacterianas en el ecosistema intestinal, medidas mediante índices como los de Shannon y Pielou. ) significativamente más bajos. Es importante destacar que esa menor diversidad predecía por sí misma una peor supervivencia, lo que creaba una cadena mecánica que iba del uso de antibióticos, pasando por la disbiosis, hasta el fracaso clínico.
Los ácidos grasos de cadena corta se perfilan como el eslabón perdido
El análisis taxonómico reveló un patrón llamativo: los pacientes que respondieron al tratamiento con CAR-T presentaban una abundancia relativa significativamente mayor de (sidenote: Bacterias productoras de AGCC Taxones bacterianos que metabolizan los sustratos alimentarios en ácidos grasos de cadena corta, como el acetato, el propionato y el butirato. ) . Concretamente, taxones como Prevotella, Ruminococcus, Butyricicoccus y la familia Clostridiaceae se encontraban en mayor cantidad en los pacientes que lograron respuestas completas o parciales. Por el contrario, los pacientes que no respondieron mostraron niveles elevados de bacterias del ácido láctico, como Lactobacillales y Enterococcus. La consecuencia funcional quedó clara cuando los investigadores midieron los metabolitos séricos. Los pacientes con mayores niveles de butirato circulante al inicio del estudio mostraron una supervivencia libre de progresión y una supervivencia global superiores. Un análisis multivariante confirmó que el butirato es un factor pronóstico independiente, y que los niveles bajos conllevan un riesgo de progresión más de seis veces mayor.
El butirato reprograma las células CAR-T para mejorar su capacidad de destrucción
Para validar el papel directo del butirato, los investigadores expusieron las células CAR-T a concentraciones fisiológicamente relevantes in vitro. Las células CAR-T estimuladas con butirato mostraron una mayor expresión de marcadores de activación, una mayor eficiencia de transducción y un cambio hacia fenotipos de memoria central, características asociadas a una mayor persistencia.
Desde el punto de vista funcional, estas células generaron una lisis específica significativamente mayor de los objetivos del linfoma en múltiples relaciones efector-objetivo. La secuenciación del transcriptoma completo reveló una regulación al alza de 145 genes implicados en la citotoxicidad, la respuesta a las quimiocinas y la proliferación de células T, mientras que los genes asociados a la senescencia se regulaban a la baja. El análisis de enriquecimiento de vías confirmó una señalización inflamatoria y una función citotóxica mejoradas. Cabe destacar que la suplementación oral con butirato en un modelo de ratón con xenoinjerto redujo significativamente la carga tumoral y prolongó la supervivencia en comparación con los controles, lo que demostró la validez del concepto in vivo.
La conclusión que se extrae de esto no es que se deba suplementar inmediatamente a todos los pacientes, sino reconocer que el eje microbiota-butirato representa un determinante modificable de la eficacia de las CAR-T que merece una evaluación prospectiva.
Los antibióticos alteran la inmunoterapia contra el cáncer por sus efectos intestinales e inmunitarios
1. García-Vicente R, et al. The Potential of the Gut Microbiota and Butyrate to Enhance CAR-T Cell Therapy in Non-Hodgkin Lymphoma. Clin Cancer Res. 2025. https://doi.org/10.1158/1078-0432.CCR-25-1676












